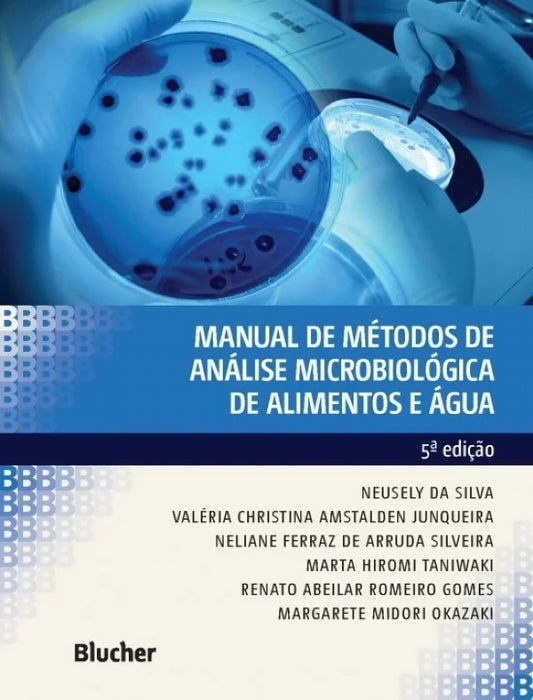

Coleção: Diversos
-
LOGÍSTICA FARMACÊUTICA NO BRASIL 2ª Edição
Preço normal R$ 100,00Preço normalPreço unitário / porR$ 180,00Preço promocional R$ 100,00Promoção -
STANDARD METHODS FOR THE EXAMINATION OF WATER AND WASTEWATER 24ª ED.
Preço normal R$ 2.690,00Preço normalPreço unitário / por -
Official Methods of Analysis of AOAC INTERNATIONAL (OMA) 22ª Edição / Print Version
Preço normal R$ 6.550,00Preço normalPreço unitário / por -
Official Methods of Analysis of AOAC INTERNATIONAL (OMA) 22ª Edição 2023 - Online Access
Preço normal R$ 6.290,00Preço normalPreço unitário / por -
Manual de Métodos de Análise Microbiológica de Alimentos e Água
Preço normal R$ 297,00Preço normalPreço unitário / por -
A Cultura do Atendimento em Empresas de Estética e Saúde
Preço normal R$ 37,90Preço normalPreço unitário / porR$ 49,90Preço promocional R$ 37,90Promoção -
Gestão e Marketing: Aplicação à Saúde Estética
Preço normal R$ 99,00Preço normalPreço unitário / porR$ 105,00Preço promocional R$ 99,00Promoção